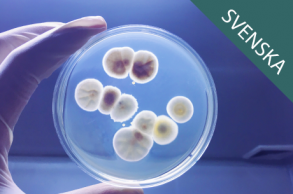
Mikrobiologi för icke-mikrobiologer - Steg 1
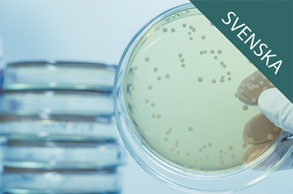
prod1

Kurser
Visar 1-14 / 14 resultat
Cleanroom Technology - An Introduction
Cleanroom Technology - An Introduction is an Online training course that provides an introduction to Cleanroom Technology: Contaminants, Cleanrooms, Standards, Cleaning and Disinfection, Cleanroom Garments and the Impact of Humans
Renrumsteknik - En introduktion
En kurs som ger en grundläggande introduktion till renrumsteknikens alla huvuddelar - Föroreningar, Renrum, Standarder och normer, Rengöring och desinfektion, Renrumskläder samt Människans roll
Practical GMP in Cleanrooms ‐ Level 1
A GMP course that provides a basic practical knowledge of GMP and how cleanrooms are used within GMP operations
Practical GMP in Cleanrooms ‐ Level 2
A GMP course that provide more in-depth knowledge of how the European GMP (Good Manufacturing Practice) affects practical work in a cleanroom, especially during the manufacture of various types of sterile pharmaceutical products.
Att arbeta i rena rum - Med mikrobiologiska renhetskrav
”Att arbeta i rena rum - Med mikrobiologiska renhetskrav” är en direkt fortsättning på ”Renrumsteknik - En introduktion” och ger kunskap och förståelse för hur man arbetar i renrum med mikrobiologiska renhetskrav.
Praktisk GMP vid renrumsarbete - Nivå 1
En kurs som ger en grundläggande praktiskt inriktad kunskap om GMP samt hur renrum används inom GMP-styrda verksamheter
Praktisk GMP vid renrumsarbete - Nivå 2
En kurs avsedd för personal med tidigare erfarenhet av renrum och renrumsarbete inom GMP verksamheter, samt som uppföljningskurs till ”Praktisk GMP vid renrumsarbete - Nivå 1”.
Mikrobiologi för icke-mikrobiologer - Steg 1
En mikrobiologikurs, utifrån perspektivet renhet och hygien, som ger en grundläggande kunskap om den mikrobiologiska världen – för alla som har kontakt med mikrobiologi i sin verksamhet.
Mikrobiologi för icke-mikrobiologer - Steg 2
Mikrobiologi för icke-mikrobiologer - Steg 2 är en direkt fortsättning på Mikrobiologi för icke-mikrobiologer - Steg 1, som utifrån perspektivet renhet och hygien ger en grundläggande inblick i mikrobiologiska begrepp, uttryck samt namn.
Rengöring och desinfektion av renrum - Del 1
Renrumskursen "Rengöring och desinfektion av renrum - Del 1" är avsedd att användas för att trygga att all renrumspersonal får nödvändig teoretisk kunskap om hur man ska arbeta med rengöring och desinfektion av renrum.
Den Nya Europeiska Standarden EN 17141 – Biocontamination Control
"Den Nya Europeiska Standarden EN 17141 – Biocontamination Control" är en specialkurs Online som genomförs direkt i webbläsaren och ger ett personligt kursintyg som går att ladda ner efter avslutad och godkänd kurs.
Nya Annex 1 (2022)
"Nya Annex 1 (2022)" är vår nya Specialkurs Online som går igenom det viktigaste i nya Annex 1 som kom i augusti 2022. Kursen genomförs direkt i webbläsaren när det passar respektive kursdeltagare och ger ett personligt kursintyg.
Grundläggande renrumskunskap för besökare och extern personal - Läkemedel
En kort grundläggande renrumskurs som säkrar externa personers kunskap samt förståelse av regler och instruktioner i samband med renrumsbesök, för att på så sätt minimera eventuella risker med besöken
Grundläggande renrumskunskap för besökare och extern personal - Medical Device
En kort grundläggande renrumskurs som säkrar externa personers kunskap samt förståelse av regler och instruktioner i samband med renrumsbesök, för att på så sätt minimera eventuella risker med besöken